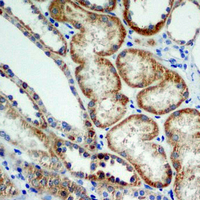

产品描述:Rabbit polyclonal antibody to BNIP3免疫原:KLH-conjugated synthetic peptide encompassing a sequence within the center region of human BNIP3. The exact sequence is proprietary.纯化方式:The antibody was purified by immunogen affinity chromatography.克隆类型:Polyclonal产品形式:Liquid in 0.42% Potassium phosphate, 0.87% Sodium chloride, pH 7.3, 30% glycerol, and 0.01% sodium azide.稀释比:WB (1/500 - 1/1000), IH (1/50 - 1/100), IF/IC (1/50 - 1/100)基因名称:BNIP3相关名称:NIP3; BCL2/adenovirus E1B 19 kDa protein-interacting protein 3
基因编号(人):
664;
蛋白编号(人):
Q12983;
储存效期:Shipped at 4°C. Upon delivery aliquot and store at -20°C for one year. Avoid freeze/thaw cycles.
-
 Western blot analysis of BNIP3 expression in HeLa (A), MCF7 (B), SHSY5Y (C), Ramos (D) whole cell lysates. (Predicted band size: 27 kD; Observed band size: 22 kD)
Western blot analysis of BNIP3 expression in HeLa (A), MCF7 (B), SHSY5Y (C), Ramos (D) whole cell lysates. (Predicted band size: 27 kD; Observed band size: 22 kD) -
Immunohistochemical analysis of BNIP3 staining in human kidney formalin fixed paraffin embedded tissue section. The section was pre-treated using heat mediated antigen retrieval with sodium citrate buffer (pH 6.0). The section was then incubated with the antibody at room temperature and detected using an HRP conjugated compact polymer system. DAB was used as the chromogen. The section was then counterstained with haematoxylin and mounted with DPX.
Immunohistochemical analysis of BNIP3 staining in human kidney formalin fixed paraffin embedded tissue section. The section was pre-treated using heat mediated antigen retrieval with sodium citrate buffer (pH 6.0). The section was then incubated with the antibody at room temperature and detected using an HRP conjugated compact polymer system. DAB was used as the chromogen. The section was then counterstained with haematoxylin and mounted with DPX. -
 Immunofluorescent analysis of BNIP3 staining in Hela cells. Formalin-fixed cells were permeabilized with 0.1% Triton X-100 in TBS for 5-10 minutes and blocked with 3% BSA-PBS for 30 minutes at room temperature. Cells were probed with the primary antibody in 3% BSA-PBS and incubated overnight at 4 °C in a humidified chamber. Cells were washed with PBST and incubated with a DyLight 594-conjugated secondary antibody (red) in PBS at room temperature in the dark.
Immunofluorescent analysis of BNIP3 staining in Hela cells. Formalin-fixed cells were permeabilized with 0.1% Triton X-100 in TBS for 5-10 minutes and blocked with 3% BSA-PBS for 30 minutes at room temperature. Cells were probed with the primary antibody in 3% BSA-PBS and incubated overnight at 4 °C in a humidified chamber. Cells were washed with PBST and incubated with a DyLight 594-conjugated secondary antibody (red) in PBS at room temperature in the dark.


 说明书
说明书 MSDS
MSDS